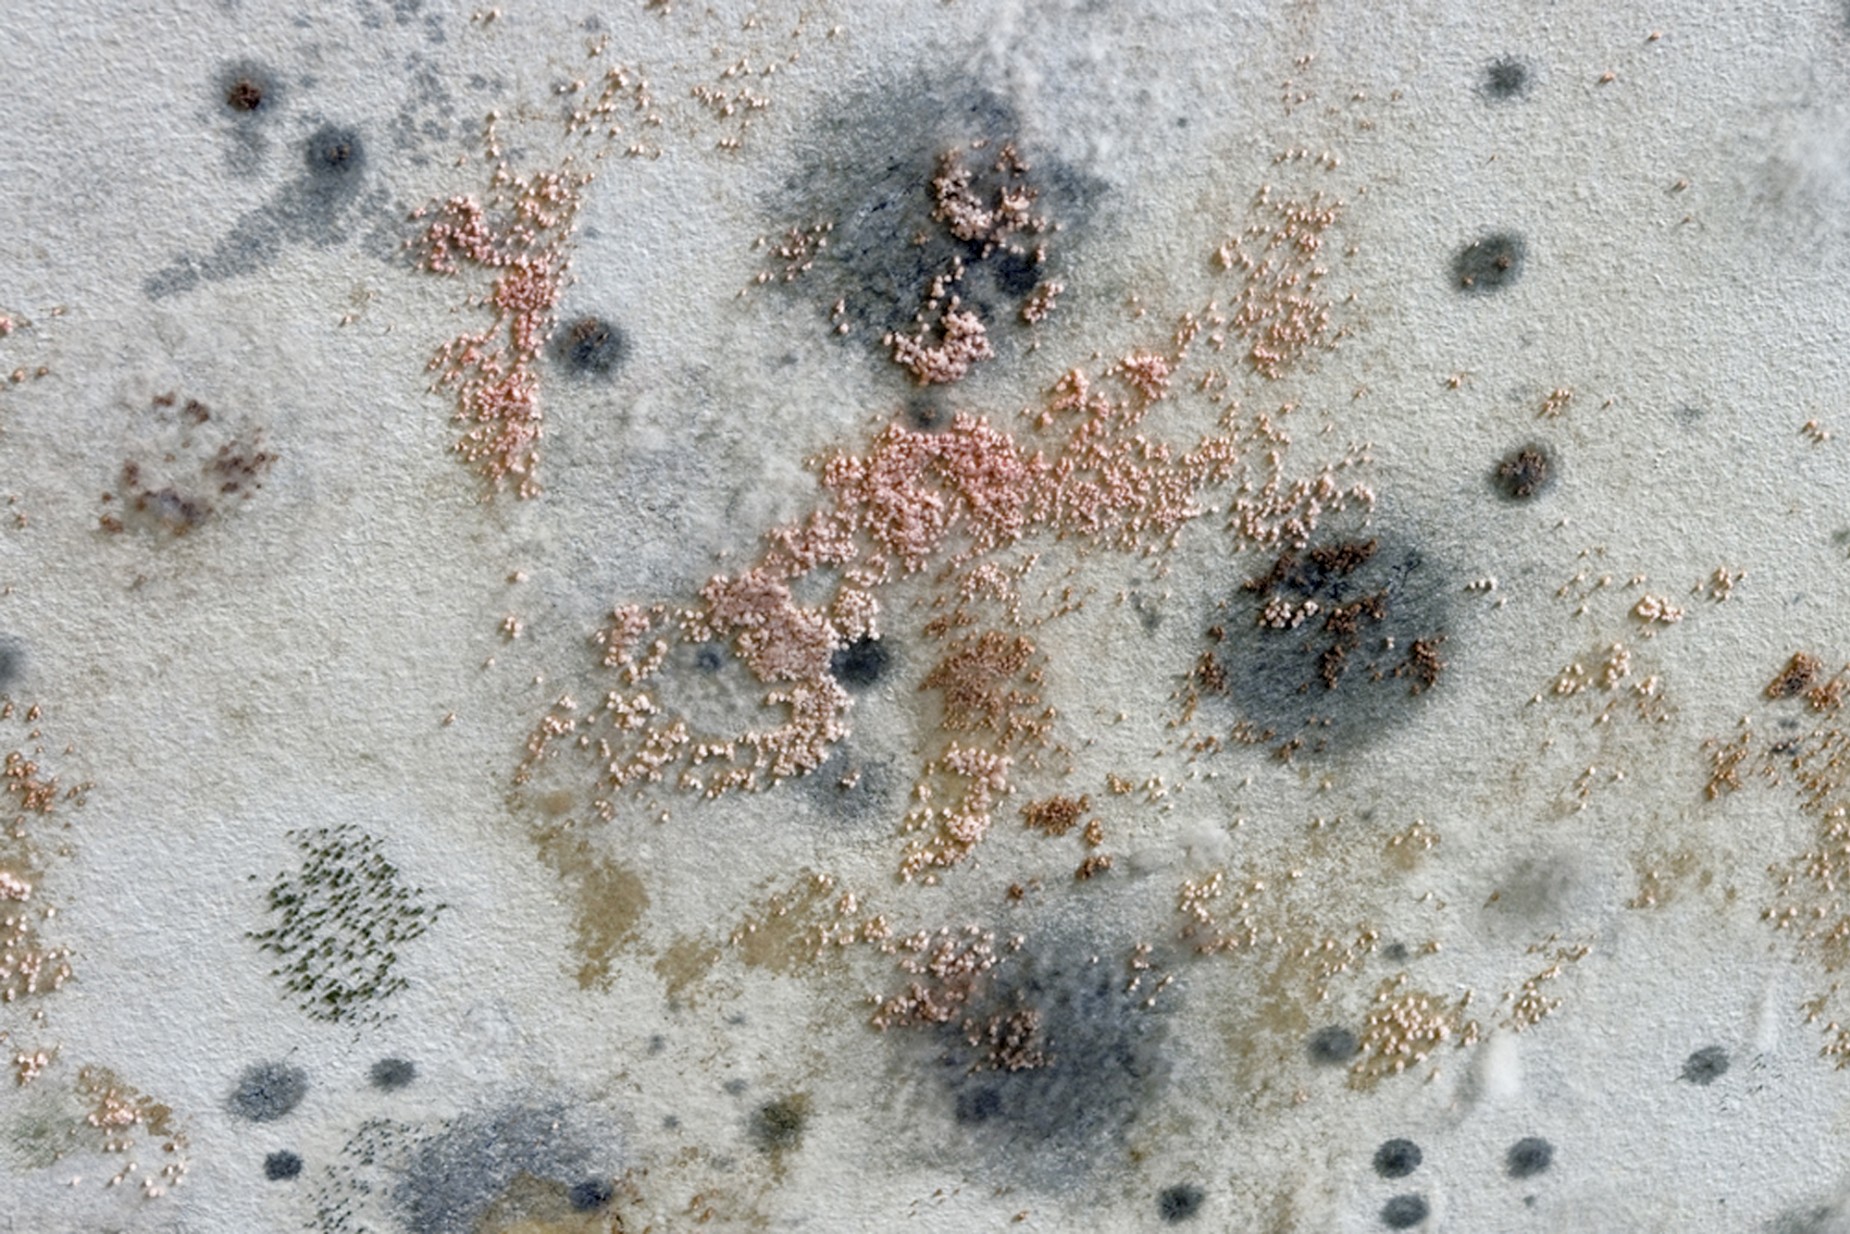

KOW Berlin
Die Gestaltung sozialer Beziehungen durch Gebautes (= Architektur und Stadtplanung) hat einen eindeutigen Trend: Homogenisierung. Städtischer Lebensraum, der einmal gemeinsam geteilt wurde oder der sich künftig hätte teilen lassen, wird heute in sozialdarwinistische Nischen zergliedert. Auf klar nach Einkommensklassen gestaffelten Stadtinseln versammelt sich seinesgleichen mit seinesgleichen.
In Berlin, wo urbane Heterogenität einmal kennzeichnend war (und sogar Wahrzeichen wurde), zeigt sich die Reorganisation von Stadt besonders deutlich als gezielte Umverteilung der Teilnahme am gesellschaftlichen Leben: Das Zentrum der Hauptstadt besetzt eine betuchte Klientel rings um neue Prestigewohnanlagen und treibt alle, die nicht mehr mitbieten können oder wollen, in Aussenbezirke. Soziale Archipele entstehen, neue Städte in der Stadt, sie alle ähnlich homogen organisiert: hier die Hartz IV-Empfänger, da eine Künstlerszene, woanders ein Migrantenviertel.
Berlin Mitte wird zur Parallelgesellschaft, die weitere Parallelgesellschaften um sich isoliert. Diese Entwicklung riskiert das Ende der Gemeinschaft, politisch befördert und kommunal subventioniert. Arno Brandlhuber reflektiert sie in seinem Doppelprojekt bei KOW und im NEUEN BERLINER KUNSTVEREIN. Als historische Folie für sein dystopisches Beschreibungsmodell des neuen Berlins zieht er einen utopischen Stadtentwurf zum Vergleich heran: „Die Stadt in der Stadt. Berlin, das Grüne Stadtarchipel“. Dessen Autoren O.M. Ungers, Rem Koolhaas, Hans Kollhoff u.a. rechneten 1977 mit der Schrumpfung der Metropole und schlugen vor, die verbleibende Bevölkerung auf gut funktionierenden urbanen Inseln zu verdichten und strukturschwache Zwischenräume zu begrünen. Heute wächst Berlin, Inseln entstehen dennoch: als Clusterstruktur sozialer Abgrenzung. Im Neuen Berliner Kunstverein inszeniert Brandlhuber die eigenlogische Fortschreibung dieser Stadtentwicklungstendenz.
Bei KOW rückt der Architekt sein eigenes Stadthaus Brunnenstrasse 9 in den Kontext dieser Problematik. Entworfen als kostengünstiges Gebäude- und Galeriemodell für heterogene Nutzungsinteressen, ist es doch selbst eine jener Mitte-Inseln, die soziale Homogenisierung verstärken. Alle Nutzer des Hauses (KOW, Redaktion 032c, Brandlhubers Architekturbüro und ein Künstleratelier) sind Akteure des kulturindustriellen Archipels, die ihresgleichen anziehen. Dass sie dies kritisch sehen mögen, ändert daran nichts. Drei Jahre nach Eröffnung der Galerie überprüft Brandlhuber nun das gemeinsame Architekturprojekt – einschließlich der Nutzungspraxis von KOW – auf Zugänglichkeit und Kritikfähigkeit. Türen und Tore der Galerie sperrt er demonstrativ auf, blockiert aber das Kellergeschoss, indem er es flutet – eine Rückschau auf den Ausgangszustand der einst feuchten Bauruine, auf der sein Neubau entstand. Das Wasser unterbricht Zugang und Nutzung des Galerieraums, verstärkt als Spiegelfläche indes den optischen Raumeffekt.
Akustisch füllt den Keller eine Soundarbeit Mark Bains: Seismographische Sensoren im Baukörper machen dessen kleinste Vibrationen hörbar. So gibt das Haus seine Resonanz mit der Umwelt tonal in sich selbst wieder. Artikel zu Liegenschaftspolitik und Wohnungsmarkt, die Brandlhuber ein Jahr lang aus deutschen Tageszeitungen zusammentrug, druckt er erneut als Zeitung und rekapituliert so jenen öffentlichen Diskursverlauf, auf den er mit stadtpolitischen Forderungen selbst Einfluss nimmt. Vergleichend lesen die Mitarbeiter von KOW und Büro Brandlhuber für Galeriebesucher täglich aus dem Grünen Stadtarchipel. Auf den Computerbildschirmen des Galerieteams, das an zwei Arbeitsinseln im Eingangsbereich zusammenrückt, laufen Werbefilme jener Mitte-Wohnparks, die heute ein für Berlin historisches Hochpreisniveau etablieren. Eine Bestandskarte städtischen Wohneigentums (WBM), über dessen Mietspiegel sich sozial gegensteuern ließe, hängt im Showroom als Edition. Titel: „Heterogenitätsmodell“.
Die Homogenisierung sozialer Beziehungen entzieht dem Gemeinwesen seine Grundlage: Vielfalt. Brandlhuber sieht die Neuaufteilung der Stadt und fordert deren heterogene Gestalt. Sein Projekt unterstreicht zugleich eigene Archipelbildungen im Kulturbetrieb – und macht damit eine Debatte über die künftige Sicherung des Rechts auf Stadt für Alle nicht einfacher, aber um so dringlicher. Wir zeigen Arno Brandlhuber (geb. 1964) als einen Diskursteilnehmer und kulturellen Produzenten, der seinen Einluß zwischen den Feldern Architektur, Kunst, Politik und Medien geltend macht. Sein erstes Einzelprojekt in einer Galerie eröffnet anlässlich des dreijährigen Bestehens von KOW und wird von KOW ISSUE 9 begleitet.
Text und Fotos: Alexander Koch